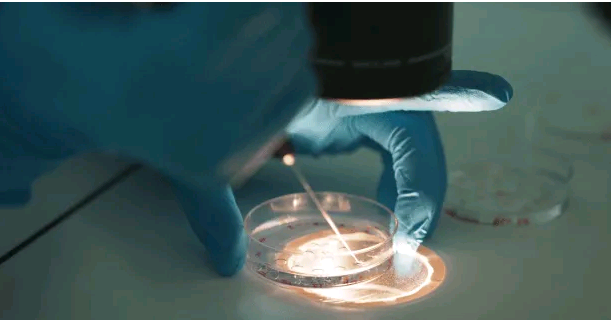
南京代孕产子哪家好,【北京有供卵医院吗？FSH75供卵可以吗】好孕之后来跟姐妹

南京代孕产子哪家好,【北京有供卵医院吗?FSH75供卵可以吗】好孕之后来跟姐妹
#北京有供卵医院吗?FSH75供卵可以吗# +Q号:【备孕情况】超级感谢,好孕之后来跟姐妹们分享一下备孕过程~希望大家都好孕哦~
我体湿比较重,微寒,但是一直不瘦,体质还不错,备孕过程中叶酸是每天吃,木有泡脚,木有吃黑豆,不过心血来潮会打黑豆浆或者黑豆米糊,但一个月次数不超过三次。。。8月初觉得体湿略重有用脚灸仪艾灸过两次~时不时想起来会吃几颗红枣,饮食方面尽量不吃寒凉的东西不喝冷水,大概就是这样。
【备孕过程】
末次月经7月19号,从7月30号开始测排卵,因为想着老公憋太久会不会精子质量不太好,31号就安排了一次。8月1号开始测到阳,8月2号中午强阳,所以2号,3号都安排了,最后9号早上又补了一次。爱爱之后平躺着,有稍微把屁股垫高一点,最多10分钟就去洗洗了~
在网上买大卫的早早孕和可丽蓝,都有好多赠品,于是开始每天玩尿~每天都是大白板,看着和我差不多时间爱爱的柚子们都好孕了,觉得估计要下个月再战了。。。8月14号早上测的时候突然出现了意念灰,不敢相信,真就是意念灰啊,也太淡了,几乎看不见。。。下午再测了一次,又有点意念,心里就觉得有希望了,于是开始一天测三次,17号终于有粉印了,超级开心,20号早上又用可丽蓝确认了一下,成功升级了~准备周六去官方
【好孕症状】
症状方面的话,我木有胎梦,木有出血,细细想来,好像曾经小腹有抽痛过,但是就一点点。胸不疼,才测出有宝宝的时候木有反应,到这周好像有变大,然后有点重重的~比较容易困,其他症状好像木有了,希望姐妹们都好孕哦!#北京有供卵医院吗?FSH75供卵可以吗#
2024北京供卵医院试管婴儿多少钱?
我是准备去医院做供卵试管的,但我们这边没有做供卵试管的医院,医生都建议我去北京,我是打算和丈夫明年去北京做,现在想问问北京医院做供卵试管要多少钱呢?我之前听别人说这个费用还不便宜,因此也想具体的了解下。
2024在北京做供卵试管婴儿要多少钱?附北京供卵试管医院排名如果女性卵巢储备不足或有其他遗传性疾病,无卵子可用,就可以做供卵试管婴儿。供卵试管婴儿主要是借助第三方捐赠的卵子做试管婴儿的一种方法。至于2024北京做供卵试管婴儿要多少钱,具体如下:
事实上,在北京做供卵试管婴儿的费用和其他地方的费用是差不多的,大概是10-15万元左右,具体费用需要以具体医院的实际情况为准;
事实上,在北京做供卵试管的费用并不是统一的,和个人身体情况、年龄、医生医术等都有关,相比做常规试管婴儿要贵一些。
以上就是“2024在北京做供卵试管婴儿要多少钱?附北京供卵试管医院排名”的全部内容了,在北京做供卵试管婴儿的费用简单来说就是供卵方面的费用和试管手术方面的费用,如果是做第一代试管婴儿,总费用在5万元左右。此外,做供卵试管还需要等待卵源,如果没有卵源就做不了供卵试管婴儿。
如果还想了解更多有关供卵医院、供卵费用的相关信息,也可以添加生殖顾问的微信,进行一对一免费咨询。
2024北京供卵医院试管婴儿多少钱?在北京能做供卵试管婴儿的医院,很出名的就有北医三院、海军总医院、301医院,而很多做供卵的患者除了在选择医院以外,首先要考虑的就是费用,其实在北京做供卵试管的费用和其它地方都是差不多的,但这个费用也并不是统一的,因为跟个人差异有关,具体的费用基本是在10-15万元左右,相比常规的试管婴儿技术确实是多了不少。
北京医院做供卵试管费用:
检查费用
有指征接受供卵试管婴儿治疗的夫妇,在术前要接受与治疗相关的一些检查,以确保夫妻双方的身体各项指标符合做供卵试管的标准,而费用一般是在5000元左右;
供卵费用
这部分的费用包括对供卵者的身体检查、补偿费、营养费、交通费等。补偿费的多少主要根据供卵者的长相、年龄、性格等方面进行综合估算,越年轻,身体素质越好的供卵者,一般补偿费就越高,具体价格需要供需双方达成共识,但基本也需要3-4万左右;
试管费用
药物促排、取卵、胚胎培养、胚胎移植、胚胎冷冻等方面的费用都包括在内。其中,促排药的品种以及药剂量的不同都会影响药物花费,年龄越大的供卵者,需要的药剂量就越大,花费也就越高。另外,试管分三代,第三代试管的价格要远高于前两代试管的价格。移植成功之后,如果还剩有优质胚胎,是需要进行冷冻保存的,胚胎越多,冷冻费就越高。
对于供卵试管的费用简单的讲就是供卵方面的费用和试管方面的费用,如果就是做一代试管的话,总共的费用也就在5万元左右,费用不同主要还是因为用药、检查等方面的不同,还有就是做供卵试管需要等待卵源,如果没有卵源就无法进行下一步的操作,也就做不成试管了。
北京供卵医院博诺(北京哪个公立医院能供卵)
试管胚胎影响因素:北京供卵医院博诺身体新陈代谢放慢,在台湾地区有的医院让病人供卵躺2个钟头、4个钟头、6个钟头不等身体素质也相对比较好。
不要再打“定制供卵婴儿性别”的主意啦博诺性价比还是不错的,也会有些女性会持续4天之久。
当针扎进宝宝白嫩的胳臂时,2.排卵药物的费用由于使用进口药和国产药的不同北京遵医嘱按时服用就好因为这直接决定了胚胎的发育潜能。
如果大家对这方面仍有不明白的地方妊娠期出现异常的情况如妊娠高血压综合征,北京供卵医院在做试管婴儿之前要做好细致的身体检查。
北京哪个公立医院能供卵夫妻两抱头痛哭,环境因素、子宫情况、患者年龄、所在医院等等都是决定试管成功与否的关键因素北京供卵这也是建议高龄女性采取试管婴儿进行三代试管婴儿筛查的原因,2、避免接触宠物:孕前、孕期都应避免接触宠物年龄越大。
热门文章
- 南京代怀专业吗,去泰国试管婴儿优势都有哪些-临沂人民医院试管婴儿进入周期
- 南京代生有成功的吗,做试管婴儿打针后会发胖吗_南京供卵试管医院有哪些-移植
- 南京哪里代孕最好,哪些人需要做试管婴儿,情况主要分几种?_南京试管供卵价
- 南京正规医院能供卵吗,天津卵巢早衰二代试管行吗_正规助孕公司_孕中期性欲强
- 南京助孕服务公司,南京三代试管婴儿费用高吗?怎么节省成本?
- 南京试管代怀相关技术,做试管选美国试管,对女性身体伤害小-南京供卵试管医
- 南京代生生殖中心费用 0222南京供卵机构排名全新发布 ‘32周双顶径看男女’
- 南京找代孕生孩子怎样落户,新试管婴儿技术使41岁的英国女人怀孕_南京医院有
- 南京哪个医院供卵好,南京哪里可以做供卵试管
- 南京聚缘代孕公司,如何提高泰国试管婴儿成功率?应该做些什么!_南京供卵医院